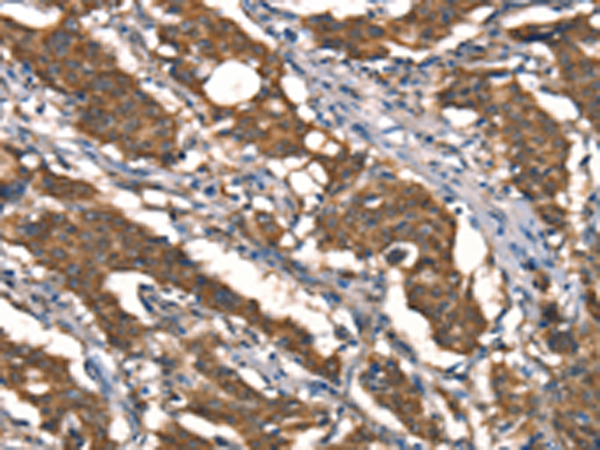

-
分类: 科研抗体货号: P11721别名: DCT1; DMT1; NRAMP2应用: IHC反应种属: Human, Mouse, Rat
-
分类: 科研抗体货号: P11707别名: SPN; NUDR; ZMYND5应用: IHC反应种属: Human
-
分类: 科研抗体货号: P11720别名: RIG; GBTS1; Di-Ras1应用: IHC反应种属: Human
-
分类: 科研抗体货号: P11705别名: G6a; DDAH; NG30; DDAHII应用: WB,IHC反应种属: Human, Mouse, Rat
-
分类: 科研抗体货号: P11719别名: D2; 5DII; SelY; DIOII; TXDI2应用: WB反应种属: Human, Mouse, Rat
-
分类: 科研抗体货号: P11704别名: DBC2应用: IHC反应种属: Human, Mouse
-
分类: 科研抗体货号: P11718别名: DCR1; MNG1; Dicer; HERNA; RMSE2应用: IHC反应种属: Human, Mouse
-
分类: 科研抗体货号: P11703别名: DAP1应用: IHC反应种属: Human, Mouse, Rat
-
分类: 科研抗体货号: P11701别名:应用: WB,IHC反应种属: Human, Mouse
-
分类: 科研抗体货号: P11702别名: AIP1; AIP-1; AF9Q34; DIP1/2应用: IHC反应种属: Human, Mouse, Rat

鄂公网安备42018502007531号
鄂公网安备42018502007531号

